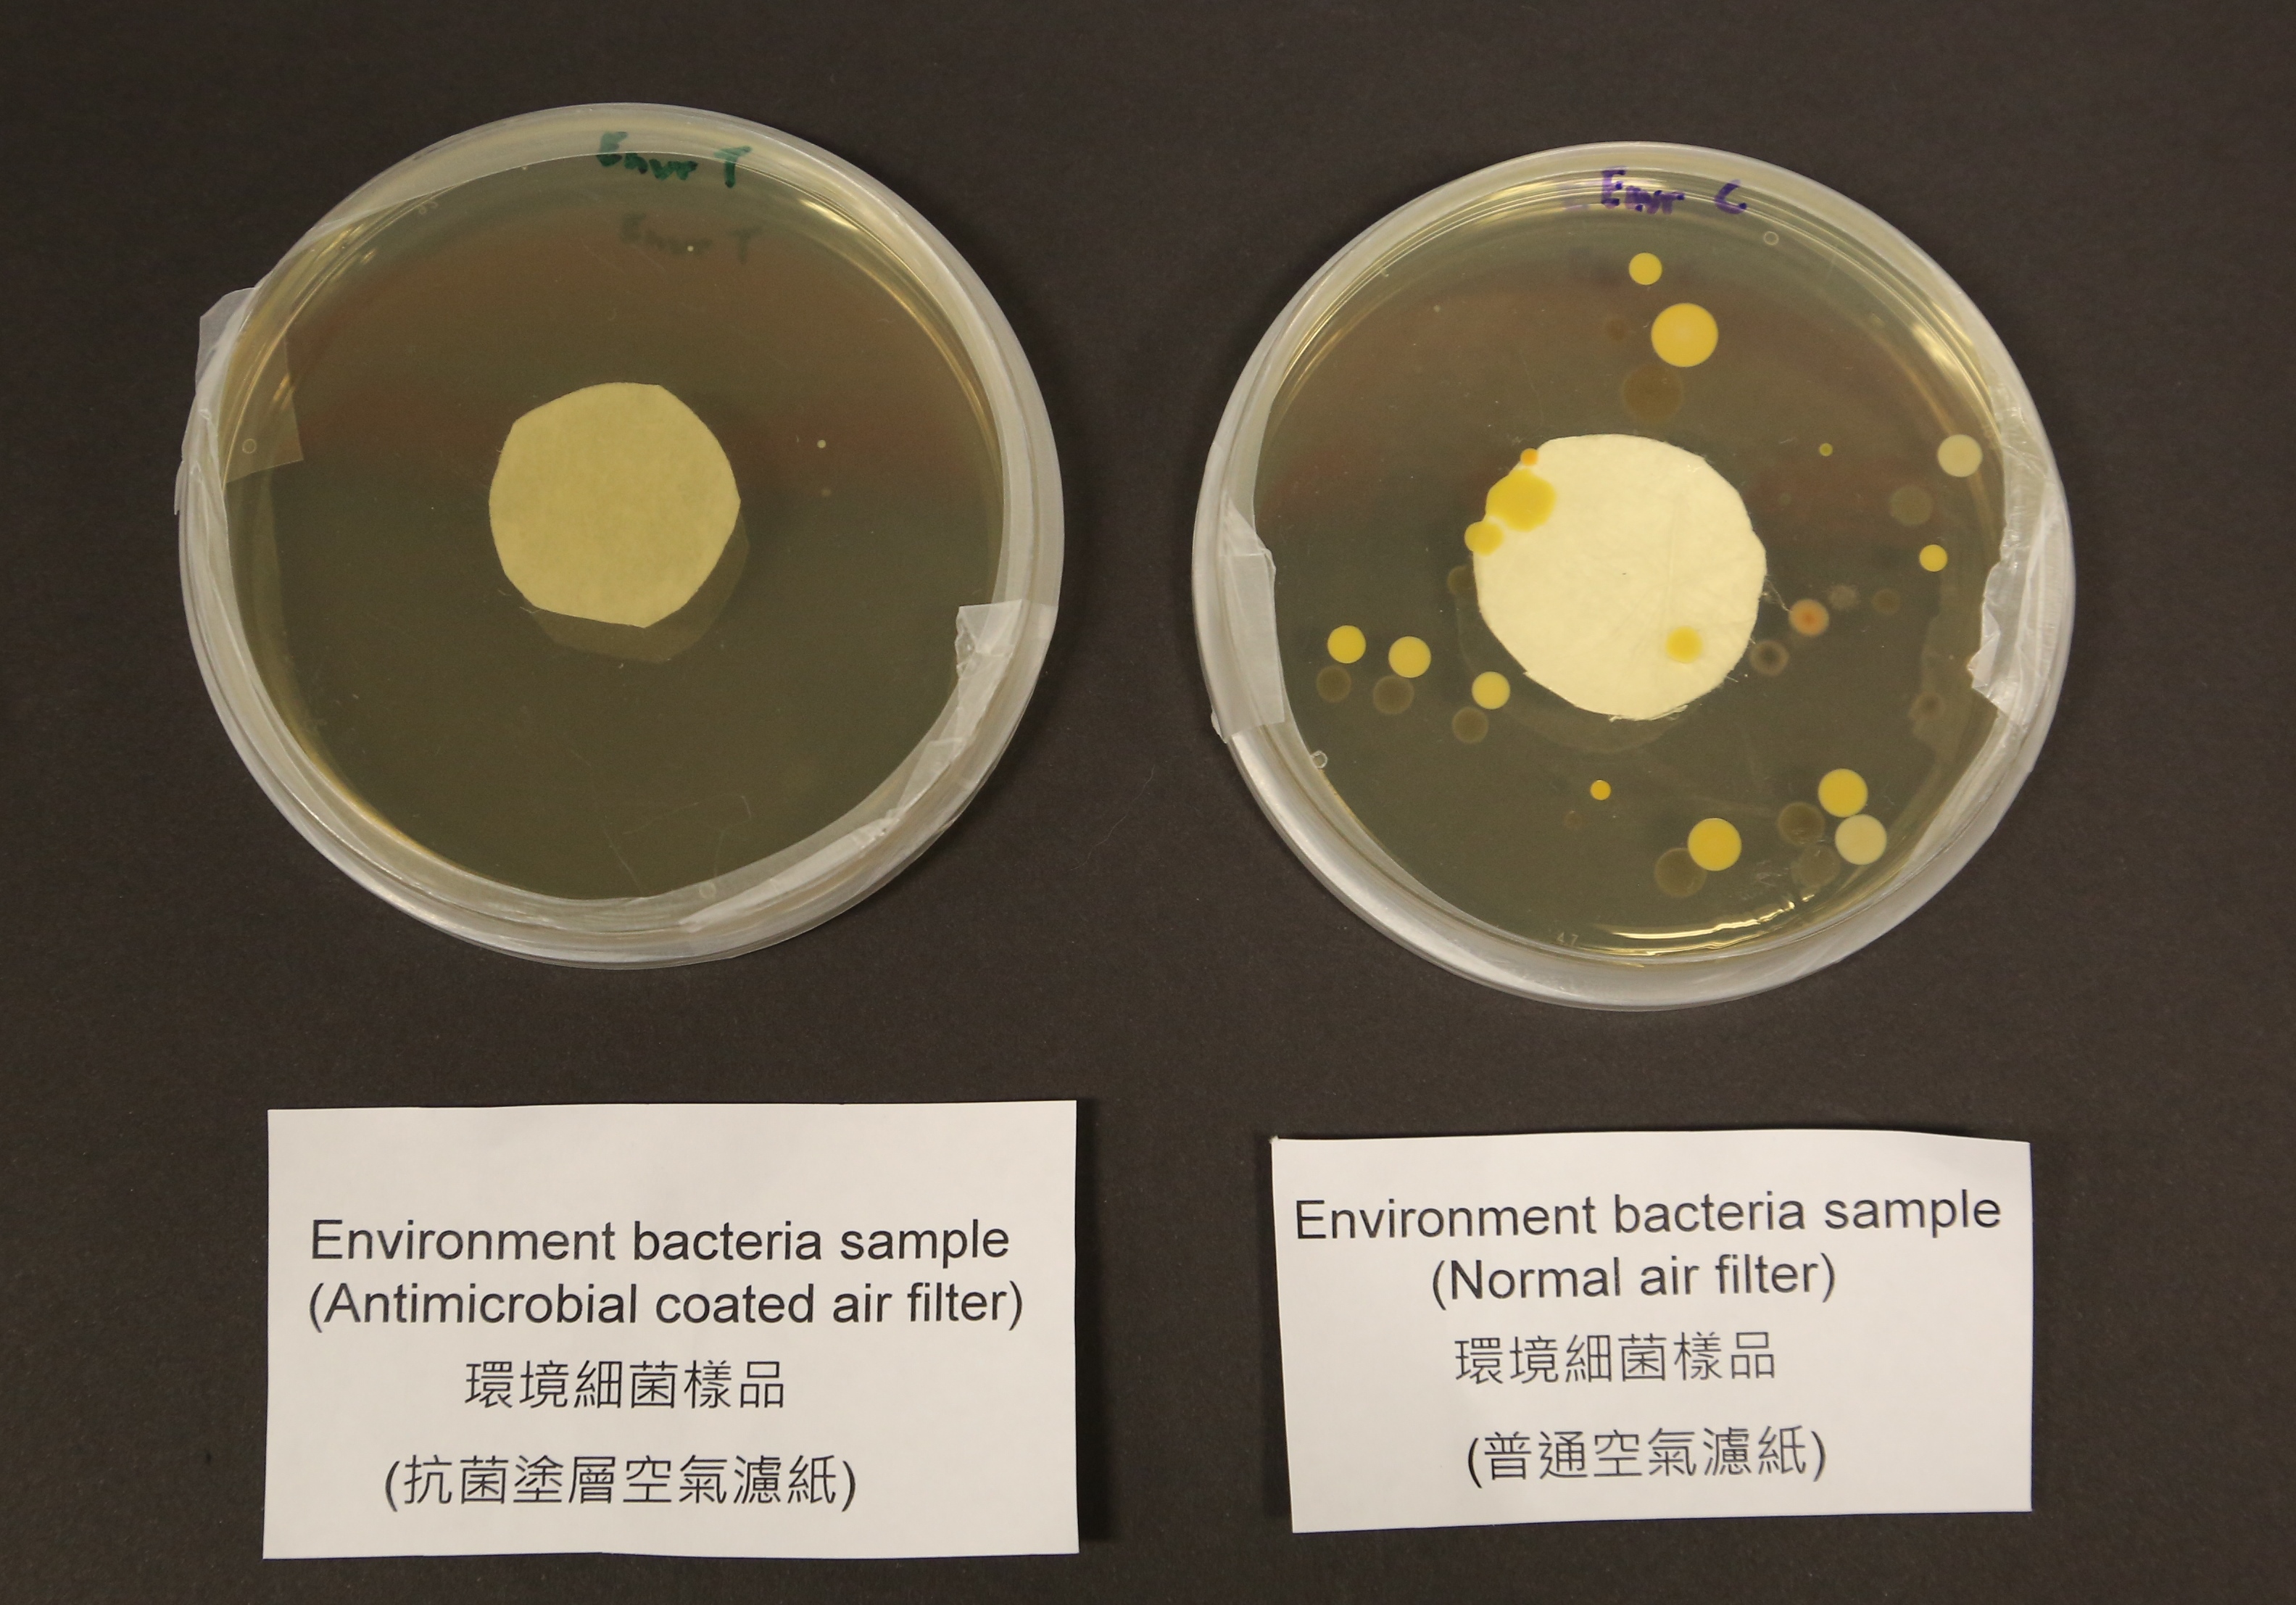
Environment bacteria sample of HKUST’s antimicrobial coated air filter (left) as compared to sample using normal air filter (right).

HKUST Develops Novel Air Purification Technology that Removes Deadly Airborne Viruses
Researchers at The Hong Kong University of Science and Technology (HKUST) have developed an air purification system that removes up to 99.999 per cent of airborne bacteria and viruses, including influenza (H1N1, H3N2), EV71 and MERS-Cov (Middle East Respiratory Syndrome Coronavirus) that had caused hundreds of deaths across the Middle East and Asia two years ago.
“Our technology effectively combats and inhibits the growth of bacteria, germs or viruses that cause respiratory diseases, offering solutions to protect one's health,” Prof Yeung King-lun, Associate Dean of Research and Graduate Studies from HKUST School of Engineering, said. “We must extend our heartfelt gratitude to Haven of Hope Christian Service, which has put our system on trial in its Holistic Care Centre for 18 months. This is the result of long cooperation among HKUST, industry and the government.”
This HKUST-developed air purification system, proven effective by Guangzhou Institute of Respiratory Disease in eliminating nearly 99% of MERS-Cov, 99.999 per cent of H1N1, over 99 per cent of H3N2 and 99 per cent of EV71 – a cause of hand-foot-and-mouth disease, has been available in the retail market as a household purifier since last September. Other HKUST lab tests also demonstrated successful elimination of a wide range of bacteria including Legionella pneumophilia, Klebsilla pneumonia, Serratia marcescens - a cause for urinary and respiratory tract infection, and Pseudomonas putida –a cause of pneumonia.
The air cleansing function is done by a multi-level antimicrobial filter covered with microcapsule emulsion which contains biocide – a substance that kill airborne micro-organisms as air passes through the filters, while the slow and continuous release of disinfectants into the air helps sterilize bacteria. The filter’s anti-adhesion coating prevents germs from sticking onto its surface, reducing the chance of microorganism growth and biofilm formation.
The technology can be incorporated into a wide range of products and applies to areas such as the purification of sewage discharge - a major environmental challenge in Hong Kong. The project received funding from the industry and the Innovation and Technology Commission.
About The Hong Kong University of Science and Technology
The Hong Kong University of Science and Technology (HKUST) (www.ust.hk) is a world-class research university that focuses on science, technology and business as well as humanities and social science. HKUST offers an international campus, and a holistic and interdisciplinary pedagogy to nurture well-rounded graduates with global vision, a strong entrepreneurial spirit and innovative thinking. Renowned for its academic rigor and research accomplishments, HKUST attained the highest proportion of internationally excellent research work in the Research Assessment Exercise 2014 of Hong Kong’s University Grants Committee, and is the world’s second in the latest QS’ Top 50 under 50 ranking. Its graduates were ranked 13th worldwide and top in Greater China in Global Employability University Survey 2016, while the flagship Kellogg-HKUST EMBA program of its School of Business and Management was ranked No 1 seven times by Financial Times’ Global EMBA Rankings.
For media enquiries, please contact: